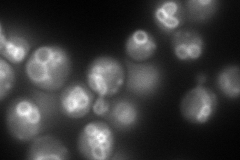
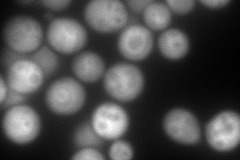
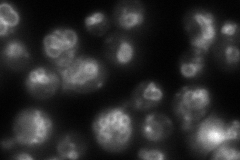
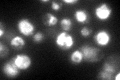

View description
Subunit H of the eight-subunit V1 peripheral membrane domain of the vacuolar H+-ATPase (V-ATPase), an electrogenic proton pump found throughout the endomembrane system; serves as an activator or a structural stabilizer of the V-ATPase
Localization:
Intensity:
Fold change:
Significance:
-
C’ GFP library in SD

vacuole membrane162.4 -
N' NOP1pr-GFP in SD
vacuole membrane244.719 -
N' TEF2pr-mCherry in SD
vacuole membrane309.181 -
N' NATIVEpr-GFP in SD
vacuole membrane125.562 -
N' TEF2pr-VC and Cyto-VN in SD

cytosol,vacuole membrane69.5029 -
C’ GFP library in SD+DTT

vacuole membrane144.220.88No -
C’ GFP library in SD+H2O2

vacuole membrane131.350.8No -
C’ GFP library in Starvation Media
vacuole membrane213.621.31No -
C’ GFP library on the background of Pup2-DaMP

vacuole membrane -
C’ GFP library on the background of CCT mutant

vacuole membrane145.1180.893528No
